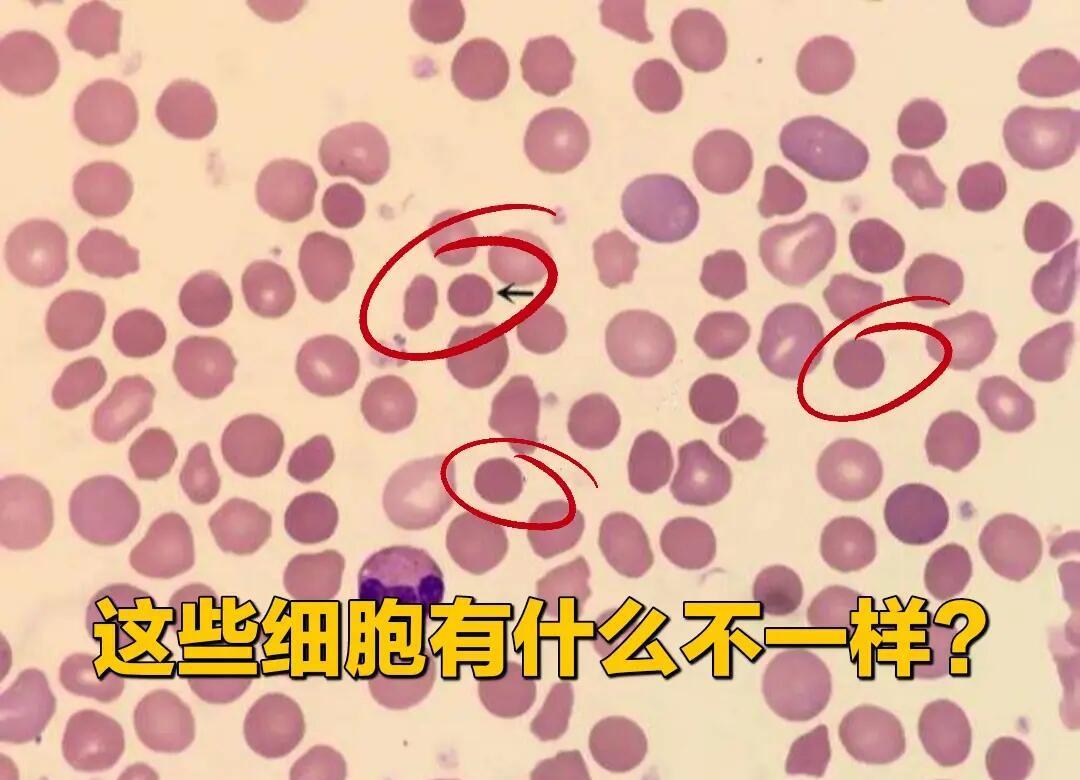

真性红细胞增多症是一种慢性骨髓增殖性肿瘤以下是关于该病症的详细解释特征主要是由于红细胞产生过多,超出了红细胞生成的正常调节机制这会导致外周血血细胞比容增加,血液黏稠度也随之增加患者常伴有白细胞和血小板升高,以及脾大并发症在病程中,患者可能出现血栓和出血等并发症,这些并发症。
真性红细胞增多症不是传统意义上的癌症,但属于血液系统中的慢性骨髓增殖性肿瘤的一种以下是关于真性红细胞增多症与癌症区别的详细解释疾病性质真性红细胞增多症虽然具有肿瘤细胞不断增殖的特性,但其分化相对成熟,疾病进展相对缓慢,生存期较长传统意义上的癌症,如肝癌肺癌等,通常具有更快的生长速度和更高。
真性红细胞增多症不是传统意义上的癌症,但属于血液系统中的慢性骨髓增殖性肿瘤的一种以下是关于真性红细胞增多症与癌症区别的详细解释疾病性质真性红细胞增多症虽然具有肿瘤细胞不断增殖的特性,但其分化相对成熟,疾病进展相对缓慢,生存期较长传统意义上的癌症,如肝癌肺癌等,通常具有更快的。
年轻人得了红细胞增多症,其生存期因红细胞增多症的类型不同而有很大差异原发性红细胞增多症此类患者,尤其是25岁以下的年轻患者较为罕见,仅占所有病例的1%该病进展缓慢,生存期通常较长然而,患者易发生血栓栓塞,晚期可能发展成为骨髓纤维化极少部分患者可能发展为急性白血病,一旦发生,大。
红细胞增多症,特别是真性红细胞增多症,是骨髓增生性疾病的一种,主要表现为克隆性红细胞增多以下是关于红细胞增多症的详细解答疾病定义真性红细胞增多症是一种骨髓异常增生导致的疾病,其特征是红细胞数量异常增多发病人群该疾病多见于中老年人,且男性患者多于女性起病通常隐匿,有时在常规。
红细胞增多的原因主要有以下几类1 血液系统疾病 真性红细胞增多症这是一种血液系统的骨髓增殖性疾病,除了红细胞增多外,还会伴有基因和染色体异常2 相对性红细胞增多症 血液浓缩常见于脱水腹泻大面积烧伤等情况,由于体液丢失导致血液浓缩,从而使得红细胞相对增多3 继发性红细胞增多症。
京公网安备11000000000001号
京ICP备11000001号
还没有评论,来说两句吧...